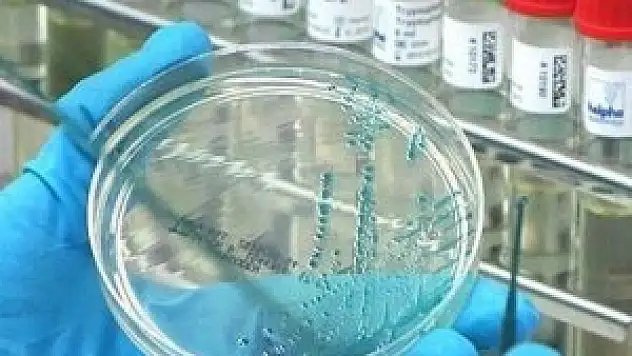
Osmaniye'de ebola şüphesi

Sağlık
Güncel sağlık haberi

ERÜ kanser ilacı üretecek

Tatil dönüşü kilo alımına dikkat!

''Sosyal medya üzerinden ilaç almayın''

Ebola virüsünü teşhis eden test geliştirildi

Sonbahar alerjisine dikkat!

Böbrek nakli ile kardeş oldular

Robotik cerrahiyle şifa buldu

Bakanlık Facebook'tan ilaç satanları takip ediyor

En çok "böbrek" en az "ince bağırsak" nakli bekleniyor

Mide kanserine karşı botoks

"Doktor balıklar" ile akvaryumda tedaviye tepki

Bunama ilaçları böbrekleri etkiliyor

Tek testle 13 farklı kanser türü teşhis edilebilecek

Sağlık Bakanlığından İngilizce "Ebola" broşürü

Kanser ilaçları sahte facebook hesabı üzerinden satılıyor

Görme engellilere 'Beyaz Baston' müjdesi

Ebolada iyileşme umudu

Menopoz yaşı uzayacak

Erkekler botoks yaptırırsa, kadınlaşır!

Beyşehir Devlet Hastanesi'nin yatakları yenilendi

Hastanede 7 ayda 226 bin hastaya poliklinik hizmeti

Aşırı tuz tüketimi ölüme götürüyor

Gebelikte 2 fincandan fazla kahve bebek için riskli

Aort diseksiyonu tanısı konulan hasta Konya'da sağlığına kavuştu

Çabuk yoruluyorsanız dikkat!

Bilgisayar göz kuruluğuna neden oluyor

Epilepsi nöbetlerine ''Pilli'' çözüm

Hava astsubayının "literatürlük" hayata dönüşü

Beyin ameliyatında keman çaldı

Salgın hızla yayılıyor
Osmaniye'de ebola şüphesi

Bebek mamasında 'anne gibi' ifadesi olmayacak

Çocuğunuzu melanomdan koruyun

Çin'den kısırlık tedavisi için yeni yöntem

Obezite 10 kanser türüne yakalanma olasılığını artırıyor

"Kıpırdama beynin patlar"

Ebola şüphesiyle gözlem altına alınan hasta taburcu edildi

Kanada'dan Ebola aşısı önerisi

Antibakteriyel sabunlar hamileler için tehlikeli olabilir

Bebeklerde beyin gelişiminin sırları ortaya çıkıyor











